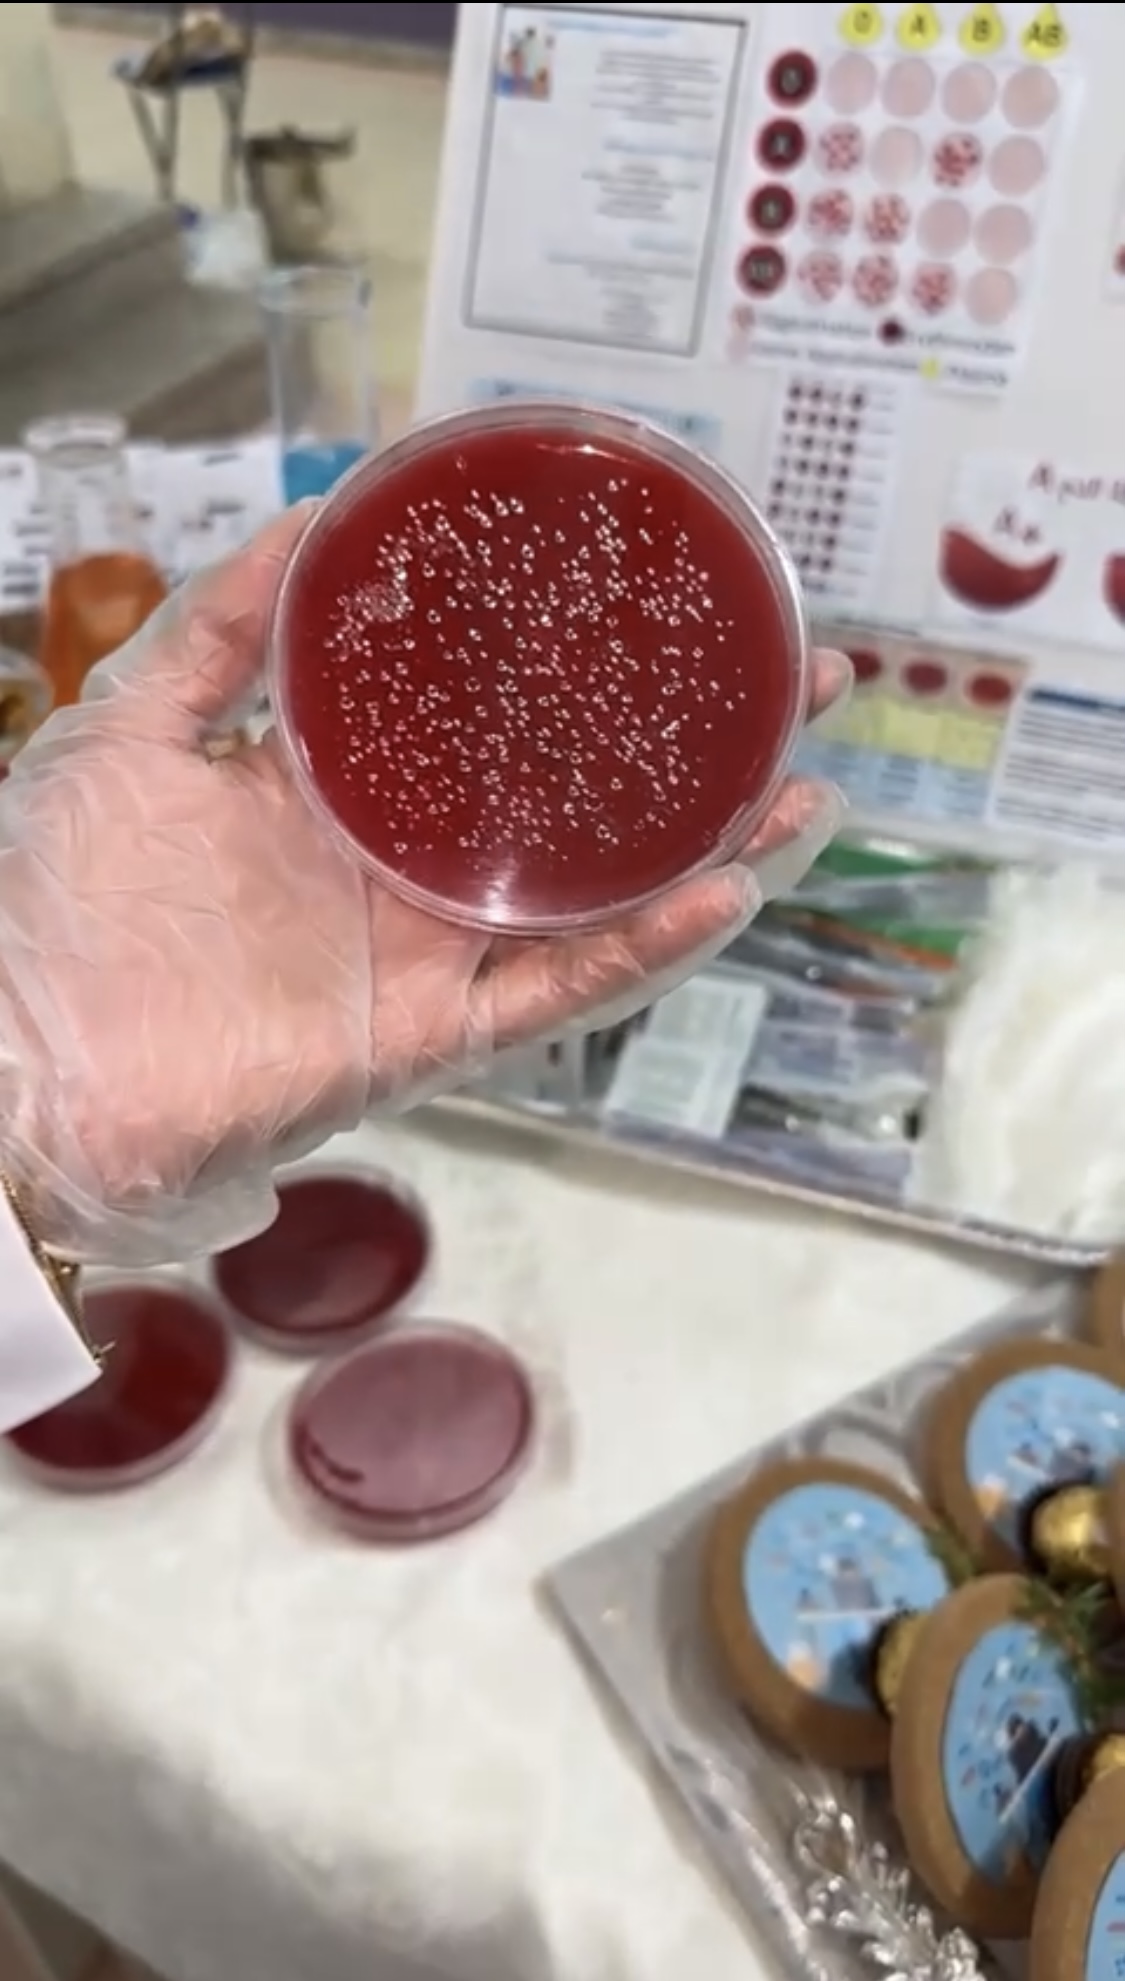

درجت جامعة الأمير سطام بن عبد العزيز على تقديم تعليم متميز يلبي حاجات سوق العمل لذا أقامت وحدة التدريب والخدمة المجتمعية بالتعاون مع وحدة القبول والتسجيل تحت رعاية عميدة كلية العلوم والدراسات الإنسانية بحوطة بني تميم د. حصة بنت سعود الهزاني برنامج تعريفي "للبرنامج المستحدثة بالكلية بالمدرسة الثانوية الثانية" وذلك يوم الاثنين الموافق ١٤٤٤/٣/٢٨هـ.
شمل البرنامج تعريف الطالبات بالبرامج الجديدة وشروط القبول بها والشهادات الاحترافية بكل برنامج كما قامت طالبات قسم الكيمياء بعمل تجارب معملية بإشراف د. مي مصطفى ود. أميرة صالح.
تاريخ آخر تعديل 05/12/2024 - 11:12 بتوقيت المملكة العربية السعودية